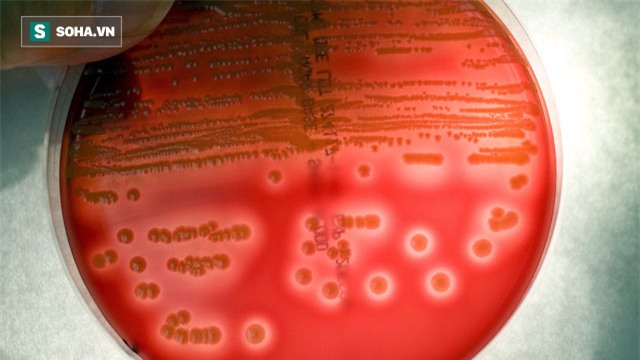
Cô gái ở HN tử vong sau 1 tuần chỉ ho, sốt: BS cảnh báo hiểm họa kinh khủng hơn cả ung thư - Ảnh 3.

Kháng kháng sinh đang trở thành hiểm hoạ toàn cầu và theo ước tính của tổ chức y tế thế giới WHO thì kháng kháng sinh sẽ trở nên kinh khủng hơn cả bệnh ung thư.
Lời cảnh báo không thừa
Trường hợp của Natalie Silva 23 tuổi, Texas Mỹ đã chết vì loại siêu vi khuẩn kháng kháng sinh sau khi sinh con trai đầu lòng tại Texas Mỹ. Loại vi khuẩn chị mắc phải là MRSA viết tắt của vi khuẩn Methicillin-resistant Staphylococcus aureus (tụ cầu vàng kháng Methicillin).
Loại vi khuẩn này gây ra nhiễm trùng "staph" không đáp ứng điều trị với kháng sinh thông thường.
Khi nhiễm MRSA sẽ dẫn đến những bệnh nhiễm trùng nghiêm trọng và đe dọa sự sống như nhiễm khuẩn huyết, nhiễm khuẩn vết mổ và viêm phổi không loại thuốc kháng sinh nào có thể điều trị được.
Còn bé Josiah Cooper-Pope qua đời khi mới 17 ngày tuổi, bị nhiễm trùng trong bệnh viện và không giữ được mạng sống vì những siêu vi khuẩn và không có loại thuốc kháng sinh nào chữa được loài siêu vi khuẩn này.
Đây chỉ là 2 trong hàng triệu người chết mỗi năm do tình trạng kháng kháng sinh gây ra.
Ông Keiji Fukuda, cố vấn đặc biệt của WHO về siêu vi khuẩn kháng thuốc cho rằng "Chúng ta đang mất đi khả năng điều trị các bệnh nhiễm trùng. Nó không chỉ dẫn đến tỉ lệ tử vong cao mà ngay cả việc điều trị cho bệnh nhân cũng bị đe dọa, thậm chí là việc cung cấp đủ thực phẩm cũng không được đảm bảo".
Điều này ám chỉ các siêu vi khuẩn có thể ảnh hưởng tới cả cây trồng, vật nuôi.
Một nghiên cứu gần đây của Anh cho thấy sự phát triển của vi khuẩn siêu kháng thể góp phần vào cái chết của 10 triệu người mỗi năm trên toàn thế giới vào năm 2050 và một lượng lớn bệnh nhân tử vong do mắc các bệnh ung thư khác nhau.
Hiện nay, số ca tử vong mỗi năm trên toàn thế giới được cho là do không có sức đề kháng chống vi khuẩn là 700.000, trong đó có 23.000 tại Hoa Kỳ.
WHO cho rằng việc ngăn chặn kháng kháng sinh cần sự vào cuộc của cộng đồng, không chia sẻ kháng sinh với người khác.
Kháng kháng sinh là nỗi đe dọa với sức khỏe và thực phẩm. Các loại kháng sinh hiện nay không còn điều trị được vì kháng thuốc. Tới năm 2050 mỗi năm có hơn 10 triệu người chết vì các bệnh lây nhiễm do vi trùng và chúng ta không có thuốc để điều trị nó.
Cái chết đau lòng tại Việt Nam chỉ sau 1 tuần ho, sốt
Tình trạng kháng kháng sinh tại Việt Nam cũng lên mức báo động đỏ khiến số người bệnh vào viện và kháng thuốc không còn cơ hội sống cũng tăng lên hàng ngày trong khi đó cuộc chạy đua giữa con người và vi khuẩn thì vi khuẩn bao giờ cũng thắng.
Trường hợp của Nguyễn Hải H. (21 tuổi), một bà mẹ đang nuôi con nhỏ 5 tháng tuổi trú tại Trương Định, Hà Nội ra đi để lại niềm thương nhớ cho cả gia đình. H. bị sụt sịt, ho và có dấu hiệu sốt. Đến ngày thứ 3 sốt truyền dịch không khỏi, H. đi vào Bệnh viện Thanh Nhàn khám.
Trong lúc chờ vào khám thì đột nhiên em ngất và các bác sĩ đưa vào cấp cứu sau đó chuyển sang Bệnh viện Bạch Mai. Sau 1 tuần điều trị tại khoa Hồi sức tích cực Bệnh viện Bạch Mai H. đã trút hơi thở cuối cùng.
Bác sĩ chẩn đoán H. bị nhiễm trùng máu, suy đa phủ tạng vì loại siêu vi khuẩn. Suốt một tuần điều trị ở Bệnh viện Bạch Mai chi phí điều trị cho H. lên tới 300 triệu đồng bởi vì các chi phí lọc máu hiện đại tốn kém nhưng cuối cùng H. vẫn không qua khỏi vì vi khuẩn cô mắc phải đã kháng thuốc.
Câu chuyện của H. gây tiếc thương cho bạn bè và đồng nghiệp của cô.
Tại Việt Nam, TS. Nguyễn Vũ Trung, Phó giám đốc Bệnh viện Bệnh Nhiệt đới Trung ương cho biết, ở nước ta ghi nhận không chỉ một mà vài loại "siêu vi khuẩn" kháng lại mọi loại thuốc kháng sinh. Phổ biến nhất là nhóm vi khuẩn gram âm đường ruột.
Chưa kể nguy cơ lây lan "siêu vi khuẩn" đa kháng thuốc trên toàn cầu do sự giao lưu thế giới ngày càng rộng rãi. Vì thế, vấn đề kháng kháng sinh là một vấn đề toàn cầu mà không một nước nào ở ngoài cuộc.
Trong khi đó, lịch sử sáng chế kháng sinh và quá trình phát triển của nó cho thấy tốc độ tìm ra kháng sinh mới không kịp so với mức độ gia tăng của vi khuẩn kháng thuốc.
Theo đó, những năm 1940 kháng sinh đầu tiên được phát minh là penicillin nhưng chỉ 10 năm sau đã xuất hiện vi khuẩn kháng loại thuốc này.
Theo TS Nguyễn Vũ Trung, tình trạng kháng kháng sinh thực sự đáng báo động tới từng người dân.
Theo Trí Thức Trẻ